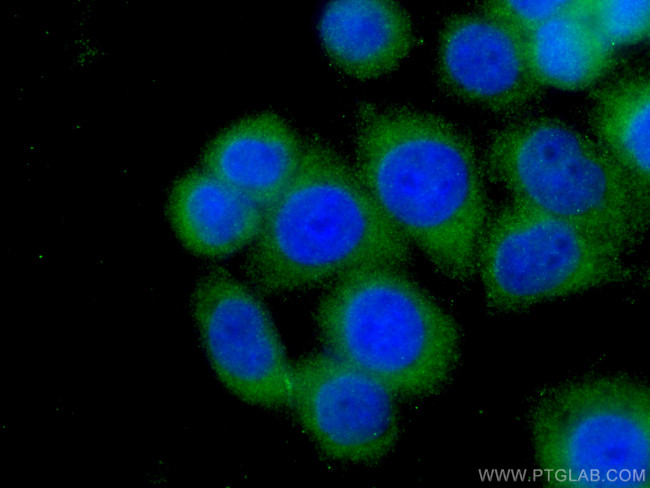
Stanniocalcin 2 Antibody in Immunocytochemistry (ICC/IF)

Search
Proteintech
Stanniocalcin 2 Monoclonal Antibody (4H1E7)
{{$productOrderCtrl.translations['antibody.pdp.commerceCard.promotion.promotions']}}
{{$productOrderCtrl.translations['antibody.pdp.commerceCard.promotion.viewpromo']}}
{{$productOrderCtrl.translations['antibody.pdp.commerceCard.promotion.promocode']}}: {{promo.promoCode}} {{promo.promoTitle}} {{promo.promoDescription}}. {{$productOrderCtrl.translations['antibody.pdp.commerceCard.promotion.learnmore']}}
产品信息
60063-1-IG
种属反应
宿主/亚型
分类
类型
克隆号
抗原
偶联物
形式
浓度
规格
纯化类型
保存液
内含物
保存条件
运输条件
产品详细信息
Immunogen sequence: TLALVLATF DPARGTDATN PPEGPQDRSS QQKGRLSLQN TAEIQHCLVN AGDVGCGVFE CFENNSCEIR GLHGICMTFL HNAGKFDAQG KSFIKDALKC KAHALRHRFG CISRKCPAIR EMVSQLQREC YLKHDLCAAA QENTRVIVEM IHFKDLLLHE PYVDLVNLLL TCGEEVKEAI THSVQVQCEQ NWGSLCSILS FCTSAIQKPP TAPPERQPQV DRTKLSRAHH GEAGHHLPEP SSRETGRGAK GERGSKSHPN AHARGRVGGL GAQGPSGSSE WE (11-291 aa encoded by BC000658)
靶标信息
Has an anti-hypocalcemic action on calcium and phosphate homeostasis.
仅用于科研。不用于诊断过程。未经明确授权不得转售。
生物信息学
蛋白别名: putative hormone; Stanniocalcin-2; Stanniocalcin-related protein; STC-2; STC-related protein; STC2; unnamed protein product
基因别名: AW125853; mustc2; STC-2; STC2; Stc2l; STCRP
UniProt ID: (Human) O76061, (Mouse) O88452
Entrez Gene ID: (Pig) 100126236, (Human) 8614, (Mouse) 20856